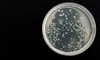

生活
梦见摘黄瓜
梦见摘黄瓜是什么兆头 1.梦见摘黄瓜,凶兆,会遇到苦难。 2.准备考试的人梦见摘黄瓜,意味着不佳,未能达到理想,秋季考稍有利。 3.创业的人梦见摘黄瓜,代表曾经数次阻碍,经营困难,冬气来时较好
梦见买柚子
梦见买柚子是什么兆头 1.梦见买,吉兆,身体会很健康。 2.病人梦见买柚子,身体不久会痊愈。 3.孕妇梦见买柚子,通常梦见买柚子都是好梦,预示梦者有好运到。孕妇梦见柚子,除了预示有好运外
梦见去读书是什么意思
梦见去读书是什么意思?五行主木,得此梦乃是学业压力大,心中多有不安之感,与他人间纠葛多者,更有烦恼之事,影响发挥,多有不顺之迹象。春天梦见去读书,五行主木,乃是才思泉涌之人,学业成绩有所改善
梦见让座位给人
梦见让座位给人是什么预兆 1.梦见让座位给人,沟通能力是这两天值得你注意的主题,你的思辨能力提升,脑袋越转越快,有助于你的成绩与业绩,在发表论述时口若悬河,给人正面有自信的形象与魅力
梦见狂犬病
梦见狂犬病是什么意思 1.梦见狂犬病,今天你的内心变得沉静,整个人也非常沉着。所以是时候停下来,脱离日常的喧嚣,审视一下你自身的情况了。若是你的工作/学业进行得不太顺利或饱受折磨
梦见细菌
梦见细菌是什么预兆梦见细菌,暗示你居住的地区可能会爆发流行病。梦见细菌的相关周公解梦 1.梦见给某地方或东西消毒,是祥兆。 2.梦见自己被感染细菌,寓意在生活中遇到了困难,工作和事业不太顺利
梦见胎动
梦见胎动是怎么回事 1.梦见胎动,吉兆,会生一个健康的男孩。 2.怀孕梦见胎动,自己和孩子都会很健康。 3.少女梦见胎动,预示着会很快找到一个意中人。 4.女人梦见胎动,会怀孕
梦见穿别人的裙子
梦到穿别人的裙子是什么意思 1.梦到穿别人的裙子,爱情容易破裂。这时要注意不可和情人吵架,吵架会导致分离的危险。 2.男性梦到穿别人的裙子,预示出远门,与伴同行吉,单独不佳。 3
梦见爱人满身是血
梦见爱人满身是血是什么预兆 1.梦见爱人满身是血,默默走向自己,这是个令人惊恐万分的梦魇,也许梦醒后你会担心自己的爱人遭遇不测。但事实上,这正是你的爱人潜意识里提醒你自己要注意身边潜伏的危机。当然
梦见被羊咬
梦见被羊咬是什么意思 1.梦见被咬,预示着生活中发生很大的改变让自己措手不及。 2.谈婚论嫁的人梦见被羊咬,说明双方意气用事,又遭受小人破坏。 3.创业的人梦见被羊咬,代表春季有阻碍
梦见抢劫别人
梦见抢劫别人 是什么预兆 1.梦见抢劫别人,预示着最近的运势一般,需要多加小心些,避免上当受骗。 2.职场新人梦见抢劫别人,预示着工作能力不错,但往往会限于独立操作的范围
梦见变年青了
梦见自己变年轻了是什么意思 1.梦见自己变年轻了,预示会遭遇悲伤、不幸,或患病。 2.男人梦见自己变年轻了,主观的言行会为你带来麻烦。这两天的气氛不怎么宽松呢
梦见收到请柬
梦见收到请柬是什么意思 1.梦见收到请柬,代表很想念远方的朋友。 2.经商人士梦见收到的请柬,预示你将被人重视,并有机会得到提拔,提高身份地位。梦见收到请柬的相关周公解梦 1.梦见接到邀请
梦见钱财被偷
梦见钱财被偷是什么预兆 1.梦到钱被偷了,预示着近期的感情运比较差,和伴侣之间较容易出现矛盾与隔阂,彼此的爱意会越来越淡,建议要谨防第三者插足,防止出现三角恋的情况。平时要多注意沟通
梦见吃冰激凌
梦见吃冰激凌是什么兆头 1.梦见吃冰激凌,是表示感情总是不如己愿,你爱的人已经另有所爱,你不爱的人却钟情于你,此时的你千万不可气馁,时间与耐心会让你完成心愿的。 2.怀孕的人梦见吃冰淇淋
梦见雀斑
梦见雀斑是什么意思梦见雀斑,象征着令人烦恼而又难以抹去的事物。 案例赏析 梦境:梦到自己跟朋友面对面坐着喝茶聊天,突然之间他的脸上开始出现小点点,自己仔细一看,发现他正在以肉眼可见的速度长出雀斑
梦见打别人
梦见打别人是什么意思 1.梦见打别人,预示你对生活可能有不满,情绪低落。或是会因为积极主动处理难题,得到别人赞扬。 2.上学的人梦见打别人,意味着口试与文科成绩差,影响录取。 3
梦见别人喝水
梦见别人喝水是什么意思 1.梦见别人喝水,象征着该留意前一日充足的睡眠与适当增添衣物;同时恋爱上有著乌云笼罩的模样;此外自由的感情姿态,让你蛮享受这段感情的
梦见自己吃泥巴
梦见自己吃泥巴是什么预兆 1.梦见自己吃泥巴,预示着自己将会脚踏实地地干事,会得到很多人的信任。 2.青年人梦见自己吃泥巴,说明这段时间您的运气非常盛,虽顺利,但避免言行过份,招惹是非
梦见打鼾
梦见打鼾是怎么回事 1.梦见打鼾,象征着生活的平稳安逸。 2.男人梦见打鼾,生活将会幸福安逸。 3.女人梦见打鼾,意味着懂得珍惜幸福,懂得心疼丈夫,会用巧妙的方法讨得丈夫的欢心。 4